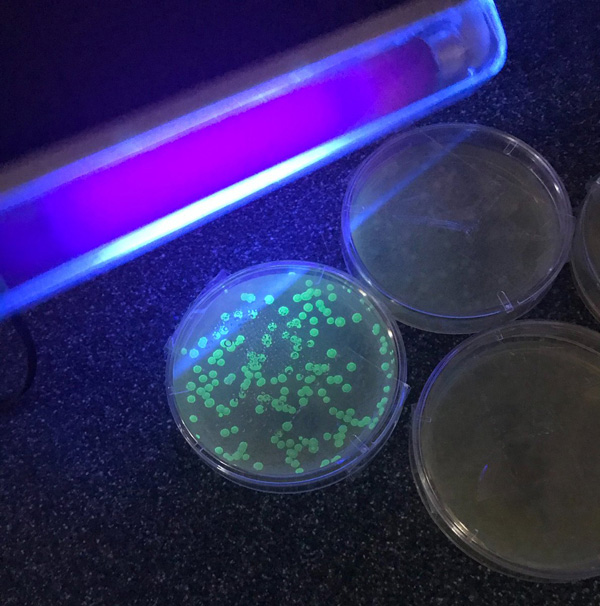
ISO 27447光催化材料抗菌活性试验
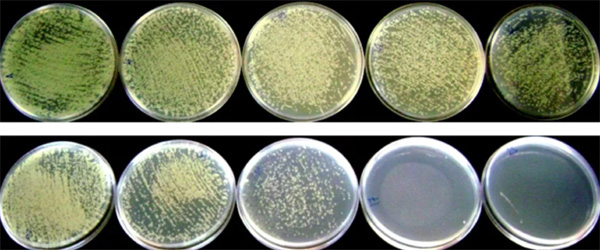
ISO 27447光催化材料抗菌活性试验

ISO 27447光催化材料抗菌活性试验

ISO 27447:2019(E)精细陶瓷(高级陶瓷,高级技术陶瓷)----半导电光催化材料 的抗菌活性试验方法
ISO 27447: 2019 Fine Ceramics (advanced ceramics, advanced technical ceramics) –Test Method for Antibacterial Activity of Semiconducting Photocatalytic Materials
ISO 27447:2019测试原理
ISO 27447:2019标准概述了一种测试方法,通过测量暴露于紫外线 (UV) 照射后的细菌数,确定含有光催化剂或表面具有光催化膜的材料的抗菌活性。固体(无孔)和纺织品都可以具有光催化剂或具有光催化膜,并且可以使用ISO 27447:2019标准方法通过检查暴露于光、紫外线后表面上可能存在的微生物的数量来进行测试。
ISO 2744:2019适用范围
ISO 27447适用于不同种类的光催化材料,这些材料应用于建筑材料中的陶瓷、瓷砖、平板、板材或纺织品,ISO 27447不适用于粉状、粒状或多孔光催化材料。

ISO 27447:2019测试概述
ISO 27447:2019的测试方法有两种:一种是在测试材料上接种细菌悬浮液后覆盖玻璃片的方法,适用于用于织物和纺织产品的测试;另一种是用透明贴膜覆盖的方法,用于平板、板材和其他材料的测试。玻璃片覆盖法使用金黄色葡萄球菌和肺炎克雷伯菌,透明贴膜覆盖法使用金黄色葡萄球菌和大肠杆菌。

在这两种方法中,测试材料都放在培养皿,试样分为以下几组:
◉ 无光催化产品的空白对照组;
◉ 带有光催化产品的单元和没有光催化产品的单元保持在同一个试验箱中,不暴露于紫外线辐射8h;
◉ 带有光催化产品的单元和没有光催化产品的单元保持在同一个试验箱中,暴露在紫外线辐射下8h。
ISO 27447:2019测试程序
1、将细菌(大肠杆菌或金黄色葡萄球菌)接种到测试样和控制样表面上。可以要求其他细菌菌株。
2、将样品暴露在紫外线下以及黑暗环境中一段时间,然后从测试和对照材料中提取活细菌并进行计数。
3、UV照射后光催化剂的抗菌活性按ISO 27447:2019中的方法计算。
4、黑暗环境中的抗菌效果也会被评估并按照ISO 27447:2019的要求纳入计算。
ISO 27447:2019光照强度
按照ISO 27447:2019的规定,在测试前必须确认UV光照强度,以模拟材料的使用环境,四种光照强度分别对应不同的模拟使用环境
◉ 紫外光强度0.25mW/cm2 模拟白天在窗户旁边,在辅助灯旁边进行光催化反应的环境;
◉ 紫外光强度0.10mW/cm2模拟白天在房间里(室内,离窗户约1.5米),清晨或日落前在窗边的环境;
◉ 紫外光强度0.010mW/cm2模拟白天在房间里(室内,离窗户约3米)的环境;
紫外光强度0.0010mW/cm2模拟在没有窗户的房间里(只有室内光线),晚上在房间里(只有室内光线)环境。

赛德斯威(SATISFY)可提供ISO 27447:2019(E)精细陶瓷(高级陶瓷,高级技术陶瓷)----半导电光催化材料的抗菌活性试验方法测试服务,出具权威检测报告,并提供报告解读、数据分析、样品改善建议等服务,可联系赛德斯威客服人员进一步了解。
